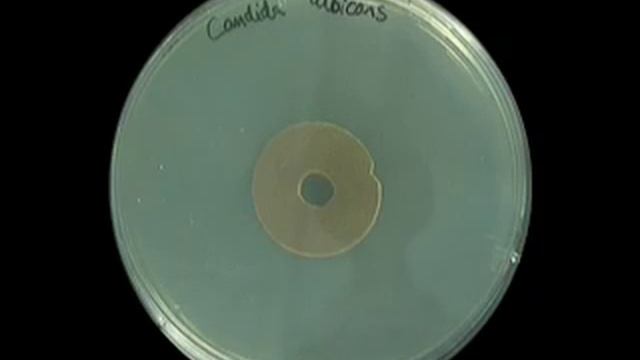
Candida Albicans - Zonex

Лесные угощения - Новые видео
-
-
Candida Albicans - Zonex
Time Lapse video of ZONEX antimicrobial catheter dressing inhibting the growth of Candida albicans (NHS clinical isolate). Visit http://www.zonex.uk.com...
Смотреть -
Збираю БІЛІ ГРИБИ, ПІДОСИНОВИКИ та ЛИСИЧКИ серед гірських лісів у Карпатах😍
Наступне відео https://youtu.be/q4RsMOCsvUc #гриби #грибиукраїни #збіргрибів
Смотреть -
PLANTS Vs Zombie ярость грибов
Аёу , здорово . Это последняя серия про ночь . Приятного просмотра и кушайте только свежие овощи)
Смотреть -
-
Aspergillus Fumigatus - Morgellons Disease The Silent Pandemic - Skin Disease, Eczema, Lyme Disease
Aspergillus Fumigatus - Morgellons Disease The Silent Pandemic - skin disease, eczema, Lyme Disease Morgellons.us ===================================...
Смотреть -
-
-
-
[JAK 4] Ep 1: Valentine's Paandar Steak And Eggs
Juday and Ryan celebrate an early Valentine's day with a simple yet incredibly delicious dish, "Valentine's Paandar Steak and Eggs."
Смотреть -
-
-
Chugging Mimosas At Brunch, Whole Foods Haul, My Morning Routine + More!
In this weeks vlog I show you guys my usual morning routine on my day off, visit governors island here in NYC which is beautiful for bike riding. Brunch...
Смотреть -
-
Заказ малютка Yves Rocher (Ив Роше)
Всем Привет Это мой заказ Ив Роше! Надеюсь вам понравилось это видео!!! Не забудьте поставить пальчик вверх и подписаться, оставляйте комментарии=)
Смотреть -
-
Три рецепта постных котлет.
#бюджетнаяеда #вгостяхусветланы #вкусныерецепты #бюджетныерецепты #вкуснаяеда #вкусныйсуп #вкусныйужин #едабезтруда #заготовкиназиму #выпечкасмясом #кот...
Смотреть -
Отправка 3-х грузов ТК "ПЭК" от 12.03.2024
Отправка 3-х грузов ТК "ПЭК" от 12.03.2024 1. Двигатель ВАЗ 11186 (комплектация блок в сборе) в г. Краснодар 2. Двигатель ВАЗ 21213 (комплектация №1 двс...
Смотреть -
Закалка трубы для буровых штанг ГНБ. ООО "Тизар"
После всех операций термообработки трубы достигают механических свойств группы прочности S-135.
Смотреть -

![[JAK 4] Ep 1: Valentine's Paandar Steak And Eggs](https://pic.rtbcdn.ru/video/2025-02-03/5c/ae/5cae7b654522c93e97ab45e481ef5bda.jpg)









